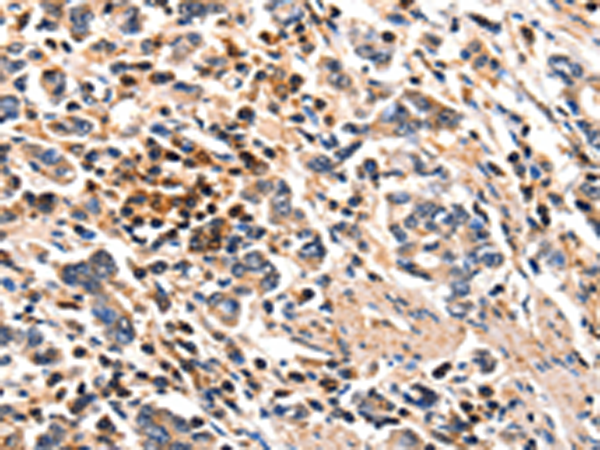

-
分类: 科研抗体货号: P10860别名: FKHL17, FREAC9, FREAC-9应用: IHC反应种属: Human, Mouse
-
分类: 科研抗体货号: P10838别名: Erb; ESRB; ESTRB; NR3A2; ER-BETA; ESR-BETA应用: WB,IHC反应种属: Human, Mouse, Rat
-
分类: 科研抗体货号: P10819别名:应用: IHC反应种属: Human, Mouse
-
分类: 科研抗体货号: P10858别名: LD; MFH1; MFH-1; FKHL14应用: WB反应种属: Human, Mouse, Rat
-
分类: 科研抗体货号: P10836别名: EPO-R应用: IHC反应种属: Human, Mouse, Rat
-
分类: 科研抗体货号: P10818别名: DP; DPI; DPII应用: IHC反应种属: Human, Mouse
-
分类: 科研抗体货号: P10834别名: EP4; EP4R应用: WB反应种属: Human
-
分类: 科研抗体货号: P10856别名: bA159H20.4应用: IHC反应种属: Human
-
分类: 科研抗体货号: P10816别名: SDY, DBND, HPS7, My031, BLOC1S8应用: IHC反应种属: Human
-
分类: 科研抗体货号: P10833别名: EP1应用: WB反应种属: Human, Mouse, Rat

鄂公网安备42018502007531号
鄂公网安备42018502007531号

